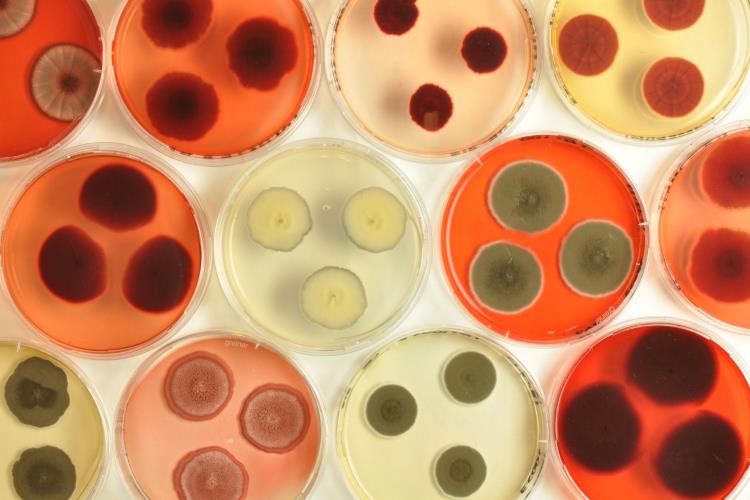

你應該要知道的食事
丹麥公司「Chromologics」利用真菌發酵,產出新型態的天然色素,成為新的天然色素取得來源,所推出的旗艦產品「ChromoRed」因顯色高、純素、加工穩定等,有望取代胭脂紅、甜菜紅等天然紅色色素。
撰文=李若威
草莓餅乾、抹茶冰淇淋、橘子汽水、素食肉排,看著市面上五顏六色的產品,不難想像色素就存在我們的生活周遭。但隨著健康意識抬頭,天然色素的需求逐漸提高,全球各大食品廠因應市場需求,也正積極研發、尋找更多的天然色素來源。
根據Mintel數據庫顯示,早在2011年,的天然色素的市場規模已達6億美元、超過合成色素的5.7億美元銷售額。而根據Hexa Research市調公司研究,全球天然色素市場的規模,預計在2025年時可達25億美元!
丹麥新創公司 利用「真菌」發酵生成天然色素!
Chromologics是一家由丹麥技術大學所創設的生物技術公司,他們為了生產新型天然色素,利用真菌發酵,產生發酵液後,再透過技術將真菌與色素分離,以取得天然色素。
而真菌由多醣體、蛋白質等物質構成,將真菌與色素分離後,色素中就不包含任何蛋白質殘留物,所以也不會引起過敏反應。因此真菌發酵生成的色素,同時符合猶太、清真和素食飲食等條件。
天然色素市場需求大 但仍存在許多挑戰
你所吃的草莓系列產品,能呈現鮮豔動人的粉紅色,許多都是來自於由「胭脂蟲」血液中所提煉出來的胭脂紅色素,因為來自於蟲體,所以並不適合素食者食用。美國星巴克的草莓星冰樂飲品中就曾因為添加由胭脂蟲製成的色素來調色,2012年遭到素食團體的強烈抗議。也反應出這類型的天然色素,無法滿足近年素食人口及純素產品日益增長的需求。
而以蔬果、植物等為來源的天然色素,加工上則會受pH值、溫度及光照等影響呈色結果,加工穩定性仍是問題。且最實際的,天然色素遠比合成色素貴的許多。
「ChromoRed」將能取代胭脂紅、甜菜根等天然紅色色素來源
Chromologics利用真菌生物發酵技術開發出來的旗艦產品天然紅色色素「ChromoRed」,根據Chromologics表示,ChromoRed能承受的pH值範圍和高溫加工條件,相較一般天然色素來得廣,仍能穩定顯色,意味著將來能廣泛用於不同產品的開發。
同時Chromologics指出,這款「ChromoRed」顯色度高,因此在使用成本上低於胭脂紅、甜菜紅等天然紅色色素,未來在產品應用上也有望取代現行常見的天然色素。

Chromologics利用真菌發酵所產生的ChromoRed天然紅色色素。(圖片來源:Chromologics官網)

用ChromoRed真菌紅色色素著色的素食漢堡肉,呈現的肉色看來相當自然。(圖片來源:Chromologics官網)
僅在實驗室就能產出 受天然環境限制少
Chromologics所產出的天然色素僅在實驗室中就能發酵生產,取代利用高價值作物或是昆蟲來提取天然色素的方法,也不像從甜菜根、薑黃等從植物中取得的天然色素會受到季節影響,也不需要耕地、甚至能省去栽種植物所需要的肥料或殺蟲劑等。就因為可以省去利用高價值作物和昆蟲提取的生產成本,Chromologics的發酵天然色素短期內雖然投入大筆研發成本,但是長遠來看,未來將可能在產品售價上提升競爭力。
目前尚未正式上市 獲600萬歐元資金投入加速生產
Chromologics日前正獲得多家食品、生物科技投資公司(Blue Horizon Ventures、Novo Seeds、Nordic Food Tech 、 Vækstfonden等)及投資人Giampaolo Cagnin等前後共600萬歐元的投資金額,同時正努力獲得美國和歐洲的監管批准,以期能早點讓真菌發酵產生的天然色素能夠合法運用於食品產業中,也希望將生產規模跨大到工業生產規模並盡快進入商業市場。
審稿編輯:李依文、林玉婷
延伸閱讀
▶發現天然食用藍色素新來源!食品巨頭瑪氏可望將其商業運用、替代人工色素!
▶紅色色素竟從「蟲蟲」提煉而來!不管害怕或吃素,新種蕃薯為你帶來新選擇!
▶全球市值上看百億!自然又繽紛的「天然色素」究竟是什麼?